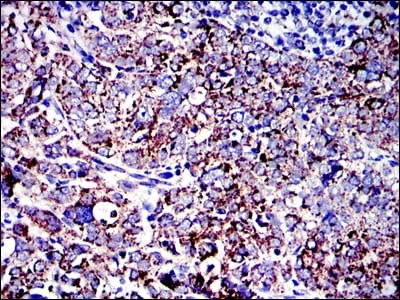

Mouse Monoclonal Antibody to AIF
货号:
30245
别名:
AIFM1; AIF; PDCD8; COXPD6; MGC111425
应用:
WB,IHC,IF,FCM
反应种属:
Human,Mouse,Rat,,Monkey
抗体类型:
Primary antibody
Swissprot:
O95831
规格:
目录价
在线咨询
Description |
|---|
This gene encodes a flavoprotein essential for nuclear disassembly in apoptotic cells, and it is found in the mitochondrial intermembrane space in healthy cells. Induction of apoptosis results in the translocation of this protein to the nucleus where it affects chromosome condensation and fragmentation. In addition, this gene product induces mitochondria to release the apoptogenic proteins cytochrome c and caspase-9. Mutations in this gene cause combined oxidative phosphorylation deficiency 6, which results in a severe mitochondrial encephalomyopathy. Alternative splicing results in multiple transcript variants. A related pseudogene has been identified on chromosome 10 |
References |
|---|
| 1. Apoptosis. 2009 Jun;14(6):796-808. 2. PLoS One. 2009;4(2):e4394. Epub 2009 Feb 6. |
Specification |
|
|---|---|
| Aliases | AIFM1; AIF; PDCD8; COXPD6; MGC111425 |
| Entrez GeneID | 9131 |
| Swissprot | O95831 |
| clone | 4E7 |
| WB Predicted band size | 67kDa |
| Host/Isotype | Mouse IgG2b |
| Antibody Type | Primary antibody |
| Storage | Store at 4°C short term. Aliquot and store at -20°C long term. Avoid freeze/thaw cycles. |
| Species Reactivity | Human,Mouse,Rat,,Monkey |
| Immunogen | Purified recombinant fragment of human AIF expressed in E. Coli. |
| Formulation | Purified antibody in PBS with 0.05% sodium azide. |
Application |
|
|---|---|
| WB | 1/500 - 1/2000 |
| IHC | 1/200 - 1/1000 |
| IF | 1/200 - 1/1000 |
| FCM | 1/200 - 1/400 |
| ELISA | 1/10000 |
Product Image
-
Red: Control Antigen (100ng); Purple: Antigen (10ng); Green: Antigen (50ng); Blue: Antigen (100ng);

-
Western blot analysis using AIF mouse mAb against NIH/3T3 (1), Jurkat (2), Hela (3), HepG2 (4), MOLT4 (5), C6 (6), RAJI (7), Cos7 (8) and PC-12 (9) cell lysate.

-
Western blot analysis using AIF mouse mAb against CHO3D10(1),COS7(2),F9(3),L1210(4),C6(5),C2C12(6),NIH/3T3(7),Raw264.7(8),PC-12(9) cell lysate.

-
Immunofluorescence analysis of NIH/3T3 cells using AIF mouse mAb (green). Blue: DRAQ5 fluorescent DNA dye. Red: Actin filaments have been labeled with Alexa Fluor-555 phalloidin.

-
Immunofluorescence analysis of RSC-96 cells using AIF mouse mAb (green). Blue: DRAQ5 fluorescent DNA dye. Red: Actin filaments have been labeled with Alexa Fluor- 555 phalloidin.

-
Immunofluorescence analysis of NIH3T3 cells using AIF mouse mAb (green). Blue: DRAQ5 fluorescent DNA dye. Red: Actin filaments have been labeled with Alexa Fluor- 555 phalloidin.

-
Flow cytometric analysis of HepG2 cells using AIF mouse mAb (blue) and negative control (red).

-
Immunohistochemical analysis of paraffin-embedded human breast cancer tissues using AIF mouse mAb with DAB staining.

-
Immunohistochemical analysis of paraffin-embedded human cervical cancer tissues using AIF mouse mAb with DAB staining.

-
Immunohistochemical analysis of paraffin-embedded human rectum cancer tissues using AIF mouse mAb with DAB staining.

-
Immunohistochemical analysis of paraffin-embedded human lung cancer tissues using AIF mouse mAb with DAB staining.

-
Immunohistochemical analysis of paraffin-embedded Mouse liver(A) Mouse kidney(B) using AIF mouse mAb with DAB staining.

-
Immunohistochemical analysis of paraffin-embedded Rat liver(A) Rat kidney(B) using AIF mouse mAb with DAB staining.

鄂公网安备42018502007531号

